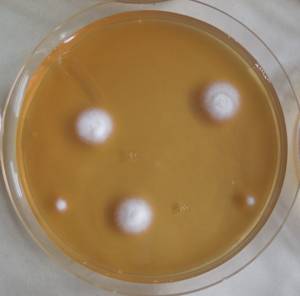
MSU_FS-03328_01, Район К Банг (K'Bang districts), Gia Lai province (Vietnam)

Total items: 6
Total pages: 1
Organisms
- Specimen ID
- 0000001189838
- Species
- Beauveria bassiana
- Strain
- MSU_FS-03328
- Place of isolation
- Район К Банг (K'Bang districts), Gia Lai province (Vietnam)
- Placename
- Кронг (Kroong (K'Rong) commune)

- Specimen ID
- 0000001189658
- Species
- Beauveria bassiana
- Strain
- MSU_FS-03229
- Place of isolation
- Район К Банг (K'Bang districts), Gia Lai province (Vietnam)
- Placename
- Кронг (Kroong (K'Rong) commune)

- Specimen ID
- 0000000905394
- Species
- Beauveria bassiana
- Strain
- MSU_FS-02304
- Place of isolation
- Район Лак (Lắk district), Đắk Lắk province (Vietnam)
- Placename
- Бонг Кранг (Bông Krang)

- Specimen ID
- 0000000904978
- Species
- Beauveria bassiana
- Strain
- MSU_FS-01957
- Place of isolation
- Район Лак (Lắk district), Đắk Lắk province (Vietnam)
- Placename
- Бонг Кранг (Bông Krang)

- Specimen ID
- 0000000612698
- Species
- Beauveria bassiana
- Strain
- MSU_FS-02800
- Place of isolation
- Одинцовский район, Moscow Oblast (Russia)
- Placename
- Звенигородская Биологическая Станция МГУ

- Specimen ID
- 0000000612875
- Species
- Beauveria bassiana
- Strain
- MSU_FS-02997
- Place of isolation
- Район Кон Плонг (Kon Plông district), Kon Tum province (Vietnam)
- Placename
- Манг Кань (Măng Cành commune)